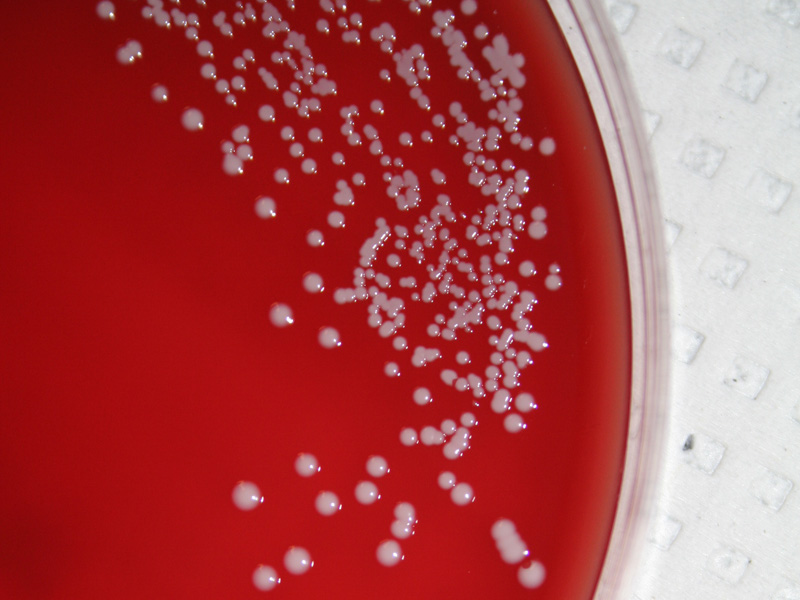

O smartphone o acompanha para cima e para baixo durante o dia e, como consequência, passa por ambientes variados e está suscetível as mesmas ameaças que você. Se estiver na chuva, por exemplo, ambos podem se molhar, e até mesmo no calor o dispositivo móvel pode sofrer um bocado. Nesse ponto, lançamos uma pergunta: no caso de bactérias, elas também são capazes de “grudar” no celular?
E a resposta é sim, caro leitor. Da mesma forma que o nosso corpo pode entrar em contato com essas bactérias, o mesmo pode ser dito sobre o seu smartphone ou outro dispositivo móvel – sendo assim, talvez seja uma boa pensar duas vezes antes de mantê-lo sobre a mesa enquanto estiver almoçando ou outros momentos como esse.
A seguir, listamos 10 dessas ameaças para que você fique por dentro dos “monstros” que podem estar próximos de você. Confira a relação mais abaixo (aliás, a ordem é totalmente aleatória e não indica qual é a mais nociva entre elas):
1. Coliformes
<button id="btn-share-image-fb" class="icon-btn icon-btn-facebook" title="Compartilhar no Facebook" aria-label="Compartilhar no Facebook" style="box-sizing: inherit; margin: 0px; font-family: inherit; font-size: 1rem; line-height: 1.25; overflow: hidden; -webkit-box-align: center; display: flex; white-space: nowrap; vertical-align: middle; user-select: none; border-width: 0px; border-style: solid; border-color: transparent; padding: 0px; transition: all 0.2s ease-in-out; cursor: pointer; width: 57px; height: 3.625rem; color: rgb(194, 194, 194); align-items: center; -webkit-box-pack: center; justify-content: center;"><svg class="ico ico-facebook" width="42" height="42" viewbox="0 0 50 50"><path d="M23.853 4.181c-1.685.914-2.865 2.136-3.512 3.635-.605 1.409-.901 3.403-.901 6.108v.92h-4.358v8.799h4.358v23.489h10.472V23.644h5.865v-8.799h-5.865v-.781c0-1.695.348-2.121.391-2.167.225-.242.753-.375 1.482-.375 1.041 0 2.151.136 3.298.411l1.329.317 1.546-7.968-1.12-.353c-4.539-1.426-9.778-1.488-12.985.252zm10.494 4.931c-2.477-.403-4.812-.247-5.971 1.001-.736.788-1.093 2.079-1.093 3.949v3.407h5.868v3.55h-5.868v23.492H22.06V21.02h-4.356v-3.55h4.356v-3.546c0-2.305.231-4.011.688-5.067.415-.961 1.184-1.733 2.354-2.37 2.297-1.247 6.286-1.267 9.828-.374l-.583 2.999z"></path></svg></button><button id="btn-share-image-pt" class="icon-btn icon-btn-pinterest" title="Compartilhar no Pinterest" aria-label="Compartilhar no Pinterest" style="box-sizing: inherit; margin: 0px; font-family: inherit; font-size: 1rem; line-height: 1.25; overflow: hidden; -webkit-box-align: center; display: flex; white-space: nowrap; vertical-align: middle; user-select: none; border-width: 0px; border-style: solid; border-color: transparent; padding: 0px; transition: all 0.2s ease-in-out; cursor: pointer; width: 58px; height: 3.625rem; color: rgb(194, 194, 194); align-items: center; -webkit-box-pack: center; justify-content: center;"><svg class="ico ico-pinterest" width="38" height="38" viewbox="0 0 20 28"><path d="M0 9.328C0 3.562 5.281 0 10.625 0 15.531 0 20 3.375 20 8.547c0 4.859-2.484 10.25-8.016 10.25-1.313 0-2.969-.656-3.609-1.875-1.188 4.703-1.094 5.406-3.719 9L4.437 26l-.141-.156c-.094-.984-.234-1.953-.234-2.938 0-3.187 1.469-7.797 2.188-10.891-.391-.797-.5-1.766-.5-2.641 0-1.578 1.094-3.578 2.875-3.578 1.313 0 2.016 1 2.016 2.234 0 2.031-1.375 3.938-1.375 5.906 0 1.344 1.109 2.281 2.406 2.281 3.594 0 4.703-5.187 4.703-7.953 0-3.703-2.625-5.719-6.172-5.719-4.125 0-7.313 2.969-7.313 7.156 0 2.016 1.234 3.047 1.234 3.531 0 .406-.297 1.844-.812 1.844-.078 0-.187-.031-.266-.047-2.234-.672-3.047-3.656-3.047-5.703z"></path></svg></button>
Coliformes são geralmente encontrados nas nossas fezes e aparecem em grandes quantidades em vasos sanitários — um bom momento para usar aquele novo emoji, né!?. Entretanto, a superfície dos nossos dispositivos pode guardar alguns deles, mas não há motivo para pânico: se aparecerem em uma quantidade pequena dificilmente vão causar algum mal à sua saúde.
2. Escherichia Coli
<button id="btn-share-image-fb" class="icon-btn icon-btn-facebook" title="Compartilhar no Facebook" aria-label="Compartilhar no Facebook" style="box-sizing: inherit; margin: 0px; font-family: inherit; font-size: 1rem; line-height: 1.25; overflow: hidden; -webkit-box-align: center; display: flex; white-space: nowrap; vertical-align: middle; user-select: none; border-width: 0px; border-style: solid; border-color: transparent; padding: 0px; transition: all 0.2s ease-in-out; cursor: pointer; width: 57px; height: 3.625rem; color: rgb(194, 194, 194); align-items: center; -webkit-box-pack: center; justify-content: center;"><svg class="ico ico-facebook" width="42" height="42" viewbox="0 0 50 50"><path d="M23.853 4.181c-1.685.914-2.865 2.136-3.512 3.635-.605 1.409-.901 3.403-.901 6.108v.92h-4.358v8.799h4.358v23.489h10.472V23.644h5.865v-8.799h-5.865v-.781c0-1.695.348-2.121.391-2.167.225-.242.753-.375 1.482-.375 1.041 0 2.151.136 3.298.411l1.329.317 1.546-7.968-1.12-.353c-4.539-1.426-9.778-1.488-12.985.252zm10.494 4.931c-2.477-.403-4.812-.247-5.971 1.001-.736.788-1.093 2.079-1.093 3.949v3.407h5.868v3.55h-5.868v23.492H22.06V21.02h-4.356v-3.55h4.356v-3.546c0-2.305.231-4.011.688-5.067.415-.961 1.184-1.733 2.354-2.37 2.297-1.247 6.286-1.267 9.828-.374l-.583 2.999z"></path></svg></button><button id="btn-share-image-pt" class="icon-btn icon-btn-pinterest" title="Compartilhar no Pinterest" aria-label="Compartilhar no Pinterest" style="box-sizing: inherit; margin: 0px; font-family: inherit; font-size: 1rem; line-height: 1.25; overflow: hidden; -webkit-box-align: center; display: flex; white-space: nowrap; vertical-align: middle; user-select: none; border-width: 0px; border-style: solid; border-color: transparent; padding: 0px; transition: all 0.2s ease-in-out; cursor: pointer; width: 58px; height: 3.625rem; color: rgb(194, 194, 194); align-items: center; -webkit-box-pack: center; justify-content: center;"><svg class="ico ico-pinterest" width="38" height="38" viewbox="0 0 20 28"><path d="M0 9.328C0 3.562 5.281 0 10.625 0 15.531 0 20 3.375 20 8.547c0 4.859-2.484 10.25-8.016 10.25-1.313 0-2.969-.656-3.609-1.875-1.188 4.703-1.094 5.406-3.719 9L4.437 26l-.141-.156c-.094-.984-.234-1.953-.234-2.938 0-3.187 1.469-7.797 2.188-10.891-.391-.797-.5-1.766-.5-2.641 0-1.578 1.094-3.578 2.875-3.578 1.313 0 2.016 1 2.016 2.234 0 2.031-1.375 3.938-1.375 5.906 0 1.344 1.109 2.281 2.406 2.281 3.594 0 4.703-5.187 4.703-7.953 0-3.703-2.625-5.719-6.172-5.719-4.125 0-7.313 2.969-7.313 7.156 0 2.016 1.234 3.047 1.234 3.531 0 .406-.297 1.844-.812 1.844-.078 0-.187-.031-.266-.047-2.234-.672-3.047-3.656-3.047-5.703z"></path></svg></button>
Mais um tipo de coliforme que pode viver no nosso intestino, mas a sua presença em um dispositivo móvel pode indicar que algo não está indo muito bem – especialmente quando combinado com outros corpos nocivos, já que o contato externo com essas bactérias é capaz de causar diarreia, vômito e mais alguns outros resultados que não são nada agradáveis.
3. Staphylococci Coagulase-Negativas
<button id="btn-share-image-fb" class="icon-btn icon-btn-facebook" title="Compartilhar no Facebook" aria-label="Compartilhar no Facebook" style="box-sizing: inherit; margin: 0px; font-family: inherit; font-size: 1rem; line-height: 1.25; overflow: hidden; -webkit-box-align: center; display: flex; white-space: nowrap; vertical-align: middle; user-select: none; border-width: 0px; border-style: solid; border-color: transparent; padding: 0px; transition: all 0.2s ease-in-out; cursor: pointer; width: 57px; height: 3.625rem; color: rgb(194, 194, 194); align-items: center; -webkit-box-pack: center; justify-content: center;"><svg class="ico ico-facebook" width="42" height="42" viewbox="0 0 50 50"><path d="M23.853 4.181c-1.685.914-2.865 2.136-3.512 3.635-.605 1.409-.901 3.403-.901 6.108v.92h-4.358v8.799h4.358v23.489h10.472V23.644h5.865v-8.799h-5.865v-.781c0-1.695.348-2.121.391-2.167.225-.242.753-.375 1.482-.375 1.041 0 2.151.136 3.298.411l1.329.317 1.546-7.968-1.12-.353c-4.539-1.426-9.778-1.488-12.985.252zm10.494 4.931c-2.477-.403-4.812-.247-5.971 1.001-.736.788-1.093 2.079-1.093 3.949v3.407h5.868v3.55h-5.868v23.492H22.06V21.02h-4.356v-3.55h4.356v-3.546c0-2.305.231-4.011.688-5.067.415-.961 1.184-1.733 2.354-2.37 2.297-1.247 6.286-1.267 9.828-.374l-.583 2.999z"></path></svg></button><button id="btn-share-image-pt" class="icon-btn icon-btn-pinterest" title="Compartilhar no Pinterest" aria-label="Compartilhar no Pinterest" style="box-sizing: inherit; margin: 0px; font-family: inherit; font-size: 1rem; line-height: 1.25; overflow: hidden; -webkit-box-align: center; display: flex; white-space: nowrap; vertical-align: middle; user-select: none; border-width: 0px; border-style: solid; border-color: transparent; padding: 0px; transition: all 0.2s ease-in-out; cursor: pointer; width: 58px; height: 3.625rem; color: rgb(194, 194, 194); align-items: center; -webkit-box-pack: center; justify-content: center;"><svg class="ico ico-pinterest" width="38" height="38" viewbox="0 0 20 28"><path d="M0 9.328C0 3.562 5.281 0 10.625 0 15.531 0 20 3.375 20 8.547c0 4.859-2.484 10.25-8.016 10.25-1.313 0-2.969-.656-3.609-1.875-1.188 4.703-1.094 5.406-3.719 9L4.437 26l-.141-.156c-.094-.984-.234-1.953-.234-2.938 0-3.187 1.469-7.797 2.188-10.891-.391-.797-.5-1.766-.5-2.641 0-1.578 1.094-3.578 2.875-3.578 1.313 0 2.016 1 2.016 2.234 0 2.031-1.375 3.938-1.375 5.906 0 1.344 1.109 2.281 2.406 2.281 3.594 0 4.703-5.187 4.703-7.953 0-3.703-2.625-5.719-6.172-5.719-4.125 0-7.313 2.969-7.313 7.156 0 2.016 1.234 3.047 1.234 3.531 0 .406-.297 1.844-.812 1.844-.078 0-.187-.031-.266-.047-2.234-.672-3.047-3.656-3.047-5.703z"></path></svg></button>
Há algum tempo, pesquisadores de Gana descobriram que mais de 10% dos smartphones estavam contaminados por essa bactéria, que é resistente a antibióticos e pode ser encontrada na pele humana e nas partes íntimas das mulheres. Um dos pontos negativos desse organismo é o fato de ele ser resistente a antibióticos, além de poder causar infecção no sangue em alguns casos mais extremos.
4. Pseudomonas Aeruginosa
<button id="btn-share-image-fb" class="icon-btn icon-btn-facebook" title="Compartilhar no Facebook" aria-label="Compartilhar no Facebook" style="box-sizing: inherit; margin: 0px; font-family: inherit; font-size: 1rem; line-height: 1.25; overflow: hidden; -webkit-box-align: center; display: flex; white-space: nowrap; vertical-align: middle; user-select: none; border-width: 0px; border-style: solid; border-color: transparent; padding: 0px; transition: all 0.2s ease-in-out; cursor: pointer; width: 57px; height: 3.625rem; color: rgb(194, 194, 194); align-items: center; -webkit-box-pack: center; justify-content: center;"><svg class="ico ico-facebook" width="42" height="42" viewbox="0 0 50 50"><path d="M23.853 4.181c-1.685.914-2.865 2.136-3.512 3.635-.605 1.409-.901 3.403-.901 6.108v.92h-4.358v8.799h4.358v23.489h10.472V23.644h5.865v-8.799h-5.865v-.781c0-1.695.348-2.121.391-2.167.225-.242.753-.375 1.482-.375 1.041 0 2.151.136 3.298.411l1.329.317 1.546-7.968-1.12-.353c-4.539-1.426-9.778-1.488-12.985.252zm10.494 4.931c-2.477-.403-4.812-.247-5.971 1.001-.736.788-1.093 2.079-1.093 3.949v3.407h5.868v3.55h-5.868v23.492H22.06V21.02h-4.356v-3.55h4.356v-3.546c0-2.305.231-4.011.688-5.067.415-.961 1.184-1.733 2.354-2.37 2.297-1.247 6.286-1.267 9.828-.374l-.583 2.999z"></path></svg></button><button id="btn-share-image-pt" class="icon-btn icon-btn-pinterest" title="Compartilhar no Pinterest" aria-label="Compartilhar no Pinterest" style="box-sizing: inherit; margin: 0px; font-family: inherit; font-size: 1rem; line-height: 1.25; overflow: hidden; -webkit-box-align: center; display: flex; white-space: nowrap; vertical-align: middle; user-select: none; border-width: 0px; border-style: solid; border-color: transparent; padding: 0px; transition: all 0.2s ease-in-out; cursor: pointer; width: 58px; height: 3.625rem; color: rgb(194, 194, 194); align-items: center; -webkit-box-pack: center; justify-content: center;"><svg class="ico ico-pinterest" width="38" height="38" viewbox="0 0 20 28"><path d="M0 9.328C0 3.562 5.281 0 10.625 0 15.531 0 20 3.375 20 8.547c0 4.859-2.484 10.25-8.016 10.25-1.313 0-2.969-.656-3.609-1.875-1.188 4.703-1.094 5.406-3.719 9L4.437 26l-.141-.156c-.094-.984-.234-1.953-.234-2.938 0-3.187 1.469-7.797 2.188-10.891-.391-.797-.5-1.766-.5-2.641 0-1.578 1.094-3.578 2.875-3.578 1.313 0 2.016 1 2.016 2.234 0 2.031-1.375 3.938-1.375 5.906 0 1.344 1.109 2.281 2.406 2.281 3.594 0 4.703-5.187 4.703-7.953 0-3.703-2.625-5.719-6.172-5.719-4.125 0-7.313 2.969-7.313 7.156 0 2.016 1.234 3.047 1.234 3.531 0 .406-.297 1.844-.812 1.844-.078 0-.187-.031-.266-.047-2.234-.672-3.047-3.656-3.047-5.703z"></path></svg></button>
Possivelmente um dos germes mais comuns em smartphones, foi encontrado em boa parte dos 400 aparelhos analisados por pesquisadores nigerianos. Ele acaba se tornando uma ameaça maior especialmente quando descobrimos que é extremamente resistente a tratamentos depois que infecta o corpo humano (caso precise de uma comparação, as mais severas dessas infecções geralmente acontecem em pacientes que estão em unidades de terapias intensivas, as famosas UTIs).
5. Mofo
<button id="btn-share-image-fb" class="icon-btn icon-btn-facebook" title="Compartilhar no Facebook" aria-label="Compartilhar no Facebook" style="box-sizing: inherit; margin: 0px; font-family: inherit; font-size: 1rem; line-height: 1.25; overflow: hidden; -webkit-box-align: center; display: flex; white-space: nowrap; vertical-align: middle; user-select: none; border-width: 0px; border-style: solid; border-color: transparent; padding: 0px; transition: all 0.2s ease-in-out; cursor: pointer; width: 57px; height: 3.625rem; color: rgb(194, 194, 194); align-items: center; -webkit-box-pack: center; justify-content: center;"><svg class="ico ico-facebook" width="42" height="42" viewbox="0 0 50 50"><path d="M23.853 4.181c-1.685.914-2.865 2.136-3.512 3.635-.605 1.409-.901 3.403-.901 6.108v.92h-4.358v8.799h4.358v23.489h10.472V23.644h5.865v-8.799h-5.865v-.781c0-1.695.348-2.121.391-2.167.225-.242.753-.375 1.482-.375 1.041 0 2.151.136 3.298.411l1.329.317 1.546-7.968-1.12-.353c-4.539-1.426-9.778-1.488-12.985.252zm10.494 4.931c-2.477-.403-4.812-.247-5.971 1.001-.736.788-1.093 2.079-1.093 3.949v3.407h5.868v3.55h-5.868v23.492H22.06V21.02h-4.356v-3.55h4.356v-3.546c0-2.305.231-4.011.688-5.067.415-.961 1.184-1.733 2.354-2.37 2.297-1.247 6.286-1.267 9.828-.374l-.583 2.999z"></path></svg></button><button id="btn-share-image-pt" class="icon-btn icon-btn-pinterest" title="Compartilhar no Pinterest" aria-label="Compartilhar no Pinterest" style="box-sizing: inherit; margin: 0px; font-family: inherit; font-size: 1rem; line-height: 1.25; overflow: hidden; -webkit-box-align: center; display: flex; white-space: nowrap; vertical-align: middle; user-select: none; border-width: 0px; border-style: solid; border-color: transparent; padding: 0px; transition: all 0.2s ease-in-out; cursor: pointer; width: 58px; height: 3.625rem; color: rgb(194, 194, 194); align-items: center; -webkit-box-pack: center; justify-content: center;"><svg class="ico ico-pinterest" width="38" height="38" viewbox="0 0 20 28"><path d="M0 9.328C0 3.562 5.281 0 10.625 0 15.531 0 20 3.375 20 8.547c0 4.859-2.484 10.25-8.016 10.25-1.313 0-2.969-.656-3.609-1.875-1.188 4.703-1.094 5.406-3.719 9L4.437 26l-.141-.156c-.094-.984-.234-1.953-.234-2.938 0-3.187 1.469-7.797 2.188-10.891-.391-.797-.5-1.766-.5-2.641 0-1.578 1.094-3.578 2.875-3.578 1.313 0 2.016 1 2.016 2.234 0 2.031-1.375 3.938-1.375 5.906 0 1.344 1.109 2.281 2.406 2.281 3.594 0 4.703-5.187 4.703-7.953 0-3.703-2.625-5.719-6.172-5.719-4.125 0-7.313 2.969-7.313 7.156 0 2.016 1.234 3.047 1.234 3.531 0 .406-.297 1.844-.812 1.844-.078 0-.187-.031-.266-.047-2.234-.672-3.047-3.656-3.047-5.703z"></path></svg></button>
“Peraí, mas mofo não aparece apenas em comida estragada e coisa do gênero”, alguns podem se perguntar. E a resposta é que até mesmo os nossos celulares podem carregar mofo (um teste feito na Turquia revelou que 10% dos aparelhos que pertenciam a funcionários da área da saúde continham esse tipo de bactéria), sendo que a exposição direta a eles pode causar alguns problemas respiratórios e pulmonares e até mesmo febre.
6. Leveduras
<button id="btn-share-image-fb" class="icon-btn icon-btn-facebook" title="Compartilhar no Facebook" aria-label="Compartilhar no Facebook" style="box-sizing: inherit; margin: 0px; font-family: inherit; font-size: 1rem; line-height: 1.25; overflow: hidden; -webkit-box-align: center; display: flex; white-space: nowrap; vertical-align: middle; user-select: none; border-width: 0px; border-style: solid; border-color: transparent; padding: 0px; transition: all 0.2s ease-in-out; cursor: pointer; width: 57px; height: 3.625rem; color: rgb(194, 194, 194); align-items: center; -webkit-box-pack: center; justify-content: center;"><svg class="ico ico-facebook" width="42" height="42" viewbox="0 0 50 50"><path d="M23.853 4.181c-1.685.914-2.865 2.136-3.512 3.635-.605 1.409-.901 3.403-.901 6.108v.92h-4.358v8.799h4.358v23.489h10.472V23.644h5.865v-8.799h-5.865v-.781c0-1.695.348-2.121.391-2.167.225-.242.753-.375 1.482-.375 1.041 0 2.151.136 3.298.411l1.329.317 1.546-7.968-1.12-.353c-4.539-1.426-9.778-1.488-12.985.252zm10.494 4.931c-2.477-.403-4.812-.247-5.971 1.001-.736.788-1.093 2.079-1.093 3.949v3.407h5.868v3.55h-5.868v23.492H22.06V21.02h-4.356v-3.55h4.356v-3.546c0-2.305.231-4.011.688-5.067.415-.961 1.184-1.733 2.354-2.37 2.297-1.247 6.286-1.267 9.828-.374l-.583 2.999z"></path></svg></button><button id="btn-share-image-pt" class="icon-btn icon-btn-pinterest" title="Compartilhar no Pinterest" aria-label="Compartilhar no Pinterest" style="box-sizing: inherit; margin: 0px; font-family: inherit; font-size: 1rem; line-height: 1.25; overflow: hidden; -webkit-box-align: center; display: flex; white-space: nowrap; vertical-align: middle; user-select: none; border-width: 0px; border-style: solid; border-color: transparent; padding: 0px; transition: all 0.2s ease-in-out; cursor: pointer; width: 58px; height: 3.625rem; color: rgb(194, 194, 194); align-items: center; -webkit-box-pack: center; justify-content: center;"><svg class="ico ico-pinterest" width="38" height="38" viewbox="0 0 20 28"><path d="M0 9.328C0 3.562 5.281 0 10.625 0 15.531 0 20 3.375 20 8.547c0 4.859-2.484 10.25-8.016 10.25-1.313 0-2.969-.656-3.609-1.875-1.188 4.703-1.094 5.406-3.719 9L4.437 26l-.141-.156c-.094-.984-.234-1.953-.234-2.938 0-3.187 1.469-7.797 2.188-10.891-.391-.797-.5-1.766-.5-2.641 0-1.578 1.094-3.578 2.875-3.578 1.313 0 2.016 1 2.016 2.234 0 2.031-1.375 3.938-1.375 5.906 0 1.344 1.109 2.281 2.406 2.281 3.594 0 4.703-5.187 4.703-7.953 0-3.703-2.625-5.719-6.172-5.719-4.125 0-7.313 2.969-7.313 7.156 0 2.016 1.234 3.047 1.234 3.531 0 .406-.297 1.844-.812 1.844-.078 0-.187-.031-.266-.047-2.234-.672-3.047-3.656-3.047-5.703z"></path></svg></button>
Ah, leveduras. Graças a elas temos a oportunidade de produzir coisas suculentas como pizza, e podemos manter uma convivência pacífica enquanto estão no nosso sistema digestivo. Elas até podem aparecer no seu smartphone (o mesmo estudo feito na Turquia e mencionado no tópico acima encontrou essa bactéria em 1,5% dos telefones) e causar uma infecção, mas digamos que você precisaria fazer coisas muito estranhas com o seu smartphone para que isso acontecesse (e nós não vemos mencionar essas possibilidades aqui para não dar ideias erradas).
7. Clostridium Difficile
<button id="btn-share-image-fb" class="icon-btn icon-btn-facebook" title="Compartilhar no Facebook" aria-label="Compartilhar no Facebook" style="box-sizing: inherit; margin: 0px; font-family: inherit; font-size: 1rem; line-height: 1.25; overflow: hidden; -webkit-box-align: center; display: flex; white-space: nowrap; vertical-align: middle; user-select: none; border-width: 0px; border-style: solid; border-color: transparent; padding: 0px; transition: all 0.2s ease-in-out; cursor: pointer; width: 57px; height: 3.625rem; color: rgb(194, 194, 194); align-items: center; -webkit-box-pack: center; justify-content: center;"><svg class="ico ico-facebook" width="42" height="42" viewbox="0 0 50 50"><path d="M23.853 4.181c-1.685.914-2.865 2.136-3.512 3.635-.605 1.409-.901 3.403-.901 6.108v.92h-4.358v8.799h4.358v23.489h10.472V23.644h5.865v-8.799h-5.865v-.781c0-1.695.348-2.121.391-2.167.225-.242.753-.375 1.482-.375 1.041 0 2.151.136 3.298.411l1.329.317 1.546-7.968-1.12-.353c-4.539-1.426-9.778-1.488-12.985.252zm10.494 4.931c-2.477-.403-4.812-.247-5.971 1.001-.736.788-1.093 2.079-1.093 3.949v3.407h5.868v3.55h-5.868v23.492H22.06V21.02h-4.356v-3.55h4.356v-3.546c0-2.305.231-4.011.688-5.067.415-.961 1.184-1.733 2.354-2.37 2.297-1.247 6.286-1.267 9.828-.374l-.583 2.999z"></path></svg></button><button id="btn-share-image-pt" class="icon-btn icon-btn-pinterest" title="Compartilhar no Pinterest" aria-label="Compartilhar no Pinterest" style="box-sizing: inherit; margin: 0px; font-family: inherit; font-size: 1rem; line-height: 1.25; overflow: hidden; -webkit-box-align: center; display: flex; white-space: nowrap; vertical-align: middle; user-select: none; border-width: 0px; border-style: solid; border-color: transparent; padding: 0px; transition: all 0.2s ease-in-out; cursor: pointer; width: 58px; height: 3.625rem; color: rgb(194, 194, 194); align-items: center; -webkit-box-pack: center; justify-content: center;"><svg class="ico ico-pinterest" width="38" height="38" viewbox="0 0 20 28"><path d="M0 9.328C0 3.562 5.281 0 10.625 0 15.531 0 20 3.375 20 8.547c0 4.859-2.484 10.25-8.016 10.25-1.313 0-2.969-.656-3.609-1.875-1.188 4.703-1.094 5.406-3.719 9L4.437 26l-.141-.156c-.094-.984-.234-1.953-.234-2.938 0-3.187 1.469-7.797 2.188-10.891-.391-.797-.5-1.766-.5-2.641 0-1.578 1.094-3.578 2.875-3.578 1.313 0 2.016 1 2.016 2.234 0 2.031-1.375 3.938-1.375 5.906 0 1.344 1.109 2.281 2.406 2.281 3.594 0 4.703-5.187 4.703-7.953 0-3.703-2.625-5.719-6.172-5.719-4.125 0-7.313 2.969-7.313 7.156 0 2.016 1.234 3.047 1.234 3.531 0 .406-.297 1.844-.812 1.844-.078 0-.187-.031-.266-.047-2.234-.672-3.047-3.656-3.047-5.703z"></path></svg></button>
Apesar de ter um nome difícil de pronunciar, essa bactéria é capaz de causar algo que você provavelmente conhece: diarreia. Para que essa ameaça fique longe do seu smartphone é ideal limpá-lo periodicamente – em alguns casos apenas algodão dá conta do recado, mas álcool isopropílico combinado com água destilada pode ajudar bastante nessa tarefa de higienização do aparelho.
8. Streptococcus
<button id="btn-share-image-fb" class="icon-btn icon-btn-facebook" title="Compartilhar no Facebook" aria-label="Compartilhar no Facebook" style="box-sizing: inherit; margin: 0px; font-family: inherit; font-size: 1rem; line-height: 1.25; overflow: hidden; -webkit-box-align: center; display: flex; white-space: nowrap; vertical-align: middle; user-select: none; border-width: 0px; border-style: solid; border-color: transparent; padding: 0px; transition: all 0.2s ease-in-out; cursor: pointer; width: 57px; height: 3.625rem; color: rgb(194, 194, 194); align-items: center; -webkit-box-pack: center; justify-content: center;"><svg class="ico ico-facebook" width="42" height="42" viewbox="0 0 50 50"><path d="M23.853 4.181c-1.685.914-2.865 2.136-3.512 3.635-.605 1.409-.901 3.403-.901 6.108v.92h-4.358v8.799h4.358v23.489h10.472V23.644h5.865v-8.799h-5.865v-.781c0-1.695.348-2.121.391-2.167.225-.242.753-.375 1.482-.375 1.041 0 2.151.136 3.298.411l1.329.317 1.546-7.968-1.12-.353c-4.539-1.426-9.778-1.488-12.985.252zm10.494 4.931c-2.477-.403-4.812-.247-5.971 1.001-.736.788-1.093 2.079-1.093 3.949v3.407h5.868v3.55h-5.868v23.492H22.06V21.02h-4.356v-3.55h4.356v-3.546c0-2.305.231-4.011.688-5.067.415-.961 1.184-1.733 2.354-2.37 2.297-1.247 6.286-1.267 9.828-.374l-.583 2.999z"></path></svg></button><button id="btn-share-image-pt" class="icon-btn icon-btn-pinterest" title="Compartilhar no Pinterest" aria-label="Compartilhar no Pinterest" style="box-sizing: inherit; margin: 0px; font-family: inherit; font-size: 1rem; line-height: 1.25; overflow: hidden; -webkit-box-align: center; display: flex; white-space: nowrap; vertical-align: middle; user-select: none; border-width: 0px; border-style: solid; border-color: transparent; padding: 0px; transition: all 0.2s ease-in-out; cursor: pointer; width: 58px; height: 3.625rem; color: rgb(194, 194, 194); align-items: center; -webkit-box-pack: center; justify-content: center;"><svg class="ico ico-pinterest" width="38" height="38" viewbox="0 0 20 28"><path d="M0 9.328C0 3.562 5.281 0 10.625 0 15.531 0 20 3.375 20 8.547c0 4.859-2.484 10.25-8.016 10.25-1.313 0-2.969-.656-3.609-1.875-1.188 4.703-1.094 5.406-3.719 9L4.437 26l-.141-.156c-.094-.984-.234-1.953-.234-2.938 0-3.187 1.469-7.797 2.188-10.891-.391-.797-.5-1.766-.5-2.641 0-1.578 1.094-3.578 2.875-3.578 1.313 0 2.016 1 2.016 2.234 0 2.031-1.375 3.938-1.375 5.906 0 1.344 1.109 2.281 2.406 2.281 3.594 0 4.703-5.187 4.703-7.953 0-3.703-2.625-5.719-6.172-5.719-4.125 0-7.313 2.969-7.313 7.156 0 2.016 1.234 3.047 1.234 3.531 0 .406-.297 1.844-.812 1.844-.078 0-.187-.031-.266-.047-2.234-.672-3.047-3.656-3.047-5.703z"></path></svg></button>
Talvez uma das mais perigosas ameaças que podem dar as caras no seu smartphone, o Streptococcus é capaz de se manifestar nos tipos A e B. Enquanto o A pode dar as caras em crianças com infecção de garganta (mas também é capaz de causar necrose, então fique atento!), o outro pode trazer efeitos como pneumonia e infecções no sangue.
9. Coagulase Negative Staphylococci
<button id="btn-share-image-fb" class="icon-btn icon-btn-facebook" title="Compartilhar no Facebook" aria-label="Compartilhar no Facebook" style="box-sizing: inherit; margin: 0px; font-family: inherit; font-size: 1rem; line-height: 1.25; overflow: hidden; -webkit-box-align: center; display: flex; white-space: nowrap; vertical-align: middle; user-select: none; border-width: 0px; border-style: solid; border-color: transparent; padding: 0px; transition: all 0.2s ease-in-out; cursor: pointer; width: 57px; height: 3.625rem; color: rgb(194, 194, 194); align-items: center; -webkit-box-pack: center; justify-content: center;"><svg class="ico ico-facebook" width="42" height="42" viewbox="0 0 50 50"><path d="M23.853 4.181c-1.685.914-2.865 2.136-3.512 3.635-.605 1.409-.901 3.403-.901 6.108v.92h-4.358v8.799h4.358v23.489h10.472V23.644h5.865v-8.799h-5.865v-.781c0-1.695.348-2.121.391-2.167.225-.242.753-.375 1.482-.375 1.041 0 2.151.136 3.298.411l1.329.317 1.546-7.968-1.12-.353c-4.539-1.426-9.778-1.488-12.985.252zm10.494 4.931c-2.477-.403-4.812-.247-5.971 1.001-.736.788-1.093 2.079-1.093 3.949v3.407h5.868v3.55h-5.868v23.492H22.06V21.02h-4.356v-3.55h4.356v-3.546c0-2.305.231-4.011.688-5.067.415-.961 1.184-1.733 2.354-2.37 2.297-1.247 6.286-1.267 9.828-.374l-.583 2.999z"></path></svg></button><button id="btn-share-image-pt" class="icon-btn icon-btn-pinterest" title="Compartilhar no Pinterest" aria-label="Compartilhar no Pinterest" style="box-sizing: inherit; margin: 0px; font-family: inherit; font-size: 1rem; line-height: 1.25; overflow: hidden; -webkit-box-align: center; display: flex; white-space: nowrap; vertical-align: middle; user-select: none; border-width: 0px; border-style: solid; border-color: transparent; padding: 0px; transition: all 0.2s ease-in-out; cursor: pointer; width: 58px; height: 3.625rem; color: rgb(194, 194, 194); align-items: center; -webkit-box-pack: center; justify-content: center;"><svg class="ico ico-pinterest" width="38" height="38" viewbox="0 0 20 28"><path d="M0 9.328C0 3.562 5.281 0 10.625 0 15.531 0 20 3.375 20 8.547c0 4.859-2.484 10.25-8.016 10.25-1.313 0-2.969-.656-3.609-1.875-1.188 4.703-1.094 5.406-3.719 9L4.437 26l-.141-.156c-.094-.984-.234-1.953-.234-2.938 0-3.187 1.469-7.797 2.188-10.891-.391-.797-.5-1.766-.5-2.641 0-1.578 1.094-3.578 2.875-3.578 1.313 0 2.016 1 2.016 2.234 0 2.031-1.375 3.938-1.375 5.906 0 1.344 1.109 2.281 2.406 2.281 3.594 0 4.703-5.187 4.703-7.953 0-3.703-2.625-5.719-6.172-5.719-4.125 0-7.313 2.969-7.313 7.156 0 2.016 1.234 3.047 1.234 3.531 0 .406-.297 1.844-.812 1.844-.078 0-.187-.031-.266-.047-2.234-.672-3.047-3.656-3.047-5.703z"></path></svg></button>
Um teste realizado em 2011 com os celulares de alguns estudantes apontou que 15% deles estavam infectados com o Coagulase Negative Staphylococci. É um número baixo, mas ainda assim preocupante, especialmente quando observamos que ele é capaz de causar algumas infecções no sangue.
10. Corynebacterium
<button id="btn-share-image-fb" class="icon-btn icon-btn-facebook" title="Compartilhar no Facebook" aria-label="Compartilhar no Facebook" style="box-sizing: inherit; margin: 0px; font-family: inherit; font-size: 1rem; line-height: 1.25; overflow: hidden; -webkit-box-align: center; display: flex; white-space: nowrap; vertical-align: middle; user-select: none; border-width: 0px; border-style: solid; border-color: transparent; padding: 0px; transition: all 0.2s ease-in-out; cursor: pointer; width: 57px; height: 3.625rem; color: rgb(194, 194, 194); align-items: center; -webkit-box-pack: center; justify-content: center;"><svg class="ico ico-facebook" width="42" height="42" viewbox="0 0 50 50"><path d="M23.853 4.181c-1.685.914-2.865 2.136-3.512 3.635-.605 1.409-.901 3.403-.901 6.108v.92h-4.358v8.799h4.358v23.489h10.472V23.644h5.865v-8.799h-5.865v-.781c0-1.695.348-2.121.391-2.167.225-.242.753-.375 1.482-.375 1.041 0 2.151.136 3.298.411l1.329.317 1.546-7.968-1.12-.353c-4.539-1.426-9.778-1.488-12.985.252zm10.494 4.931c-2.477-.403-4.812-.247-5.971 1.001-.736.788-1.093 2.079-1.093 3.949v3.407h5.868v3.55h-5.868v23.492H22.06V21.02h-4.356v-3.55h4.356v-3.546c0-2.305.231-4.011.688-5.067.415-.961 1.184-1.733 2.354-2.37 2.297-1.247 6.286-1.267 9.828-.374l-.583 2.999z"></path></svg></button><button id="btn-share-image-pt" class="icon-btn icon-btn-pinterest" title="Compartilhar no Pinterest" aria-label="Compartilhar no Pinterest" style="box-sizing: inherit; margin: 0px; font-family: inherit; font-size: 1rem; line-height: 1.25; overflow: hidden; -webkit-box-align: center; display: flex; white-space: nowrap; vertical-align: middle; user-select: none; border-width: 0px; border-style: solid; border-color: transparent; padding: 0px; transition: all 0.2s ease-in-out; cursor: pointer; width: 58px; height: 3.625rem; color: rgb(194, 194, 194); align-items: center; -webkit-box-pack: center; justify-content: center;"><svg class="ico ico-pinterest" width="38" height="38" viewbox="0 0 20 28"><path d="M0 9.328C0 3.562 5.281 0 10.625 0 15.531 0 20 3.375 20 8.547c0 4.859-2.484 10.25-8.016 10.25-1.313 0-2.969-.656-3.609-1.875-1.188 4.703-1.094 5.406-3.719 9L4.437 26l-.141-.156c-.094-.984-.234-1.953-.234-2.938 0-3.187 1.469-7.797 2.188-10.891-.391-.797-.5-1.766-.5-2.641 0-1.578 1.094-3.578 2.875-3.578 1.313 0 2.016 1 2.016 2.234 0 2.031-1.375 3.938-1.375 5.906 0 1.344 1.109 2.281 2.406 2.281 3.594 0 4.703-5.187 4.703-7.953 0-3.703-2.625-5.719-6.172-5.719-4.125 0-7.313 2.969-7.313 7.156 0 2.016 1.234 3.047 1.234 3.531 0 .406-.297 1.844-.812 1.844-.078 0-.187-.031-.266-.047-2.234-.672-3.047-3.656-3.047-5.703z"></path></svg></button>
Apesar de ter um nome que mais lembra um feitiço vindo do universo de Harry Potter, a Corynebacterium está longe de trazer sentimentos mágicos para a sua vida. Na verdade, ela é capaz de causar difteria, uma anomalia que infecta gargantas e dificulta a respiração. Um ponto positivo? Essa bactéria não é tão comum nos smartphones, mas ainda assim é bom mantê-lo sempre limpo.